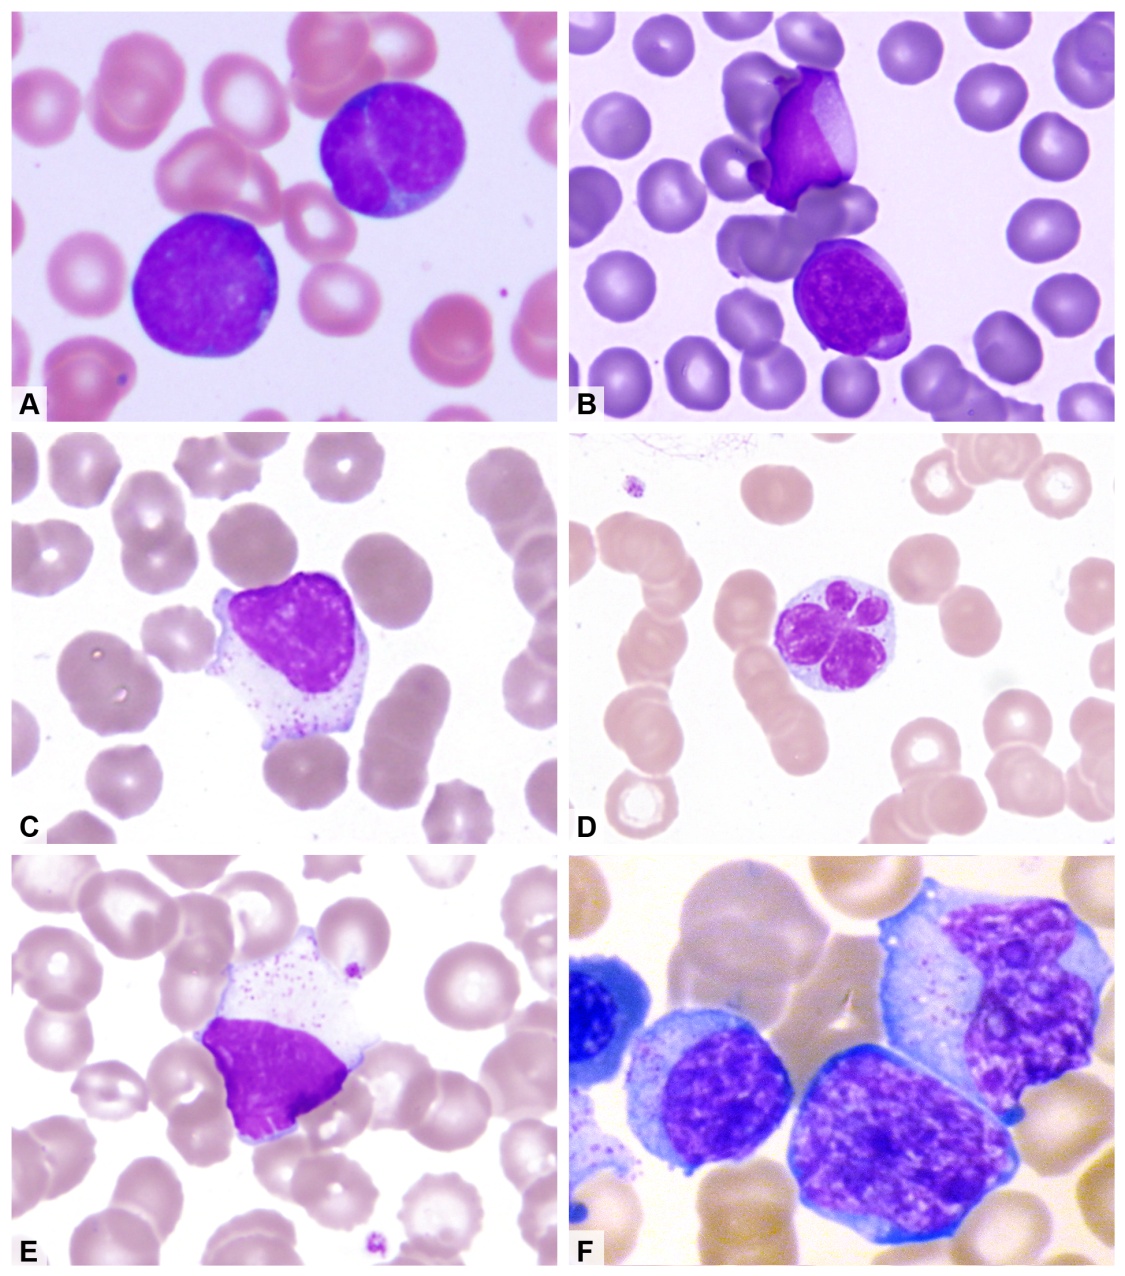

Large granular lymphocytes lgl are medium to large lymphocytes recognizable on light microscopy by their distinctive azurophilic granules fig. In this case. Large granular lymphocytic lgl leukemia is a chronic lymphoproliferative disorder that exhibits an unexplained chronic 6 months elevation in large granular lymphocytes lgls in the peripheral blood.
lymphocyte with azurophilic granules

Large granular lymphocytes lgls are 1518 mm in size having round or kidney shaped nuclei and abundant cytoplasm that contains typical azurophilic granules.
Lymphocyte with azurophilic granules. Large lymphocytes and reactive lymphocytes. An azurophilic granule is a cellular object readily stainable with a romanowsky stainin white blood cells and hyperchromatin staining imparts a burgundy or merlot coloration. These lymphocytes have been termed large granular lymphocytes lgls. Ultrastructural and cytochemical characterization of the granules.
Large lymphocytes have abundant pale blue transparent cytoplasm. One is the natural killer nk lgls that express. In normal human peripheral blood there is a population of large lymphocytes with slightly eccentric nuclei and abundant pale blue cytoplasm containing many azurophilic granules. Although there are usually no cytoplasmic granules present a few large well defined azurophilic granules lysozomes can occasionally be seen.
Neutrophils in particular are known for containing azurophils loaded with a wide variety of anti microbial defensins that fuse with phagocytic vacuolesazurophils may contain myeloperoxidase phospholipase a2 acid. Lave as maos pratique o distanciamento social e confira nossos recursos para se adaptar a estes tempos. Normally lgls make up to 1015 of peripheral blood mononuclear cells pbmcs. It is now clear that almost all natural killer and.
Azurophilic granules contain two classes of antimicrobial proteins. Mantenha se saudavel e protegidoa. Grossi ce cadoni a zicca a leprini a ferrarini m. Large granular lymphocytes lgl are defined as nonadherent mononuclear cells with cytoplasmic azurophilic granules avid receptors for the fc portion of igg and cytotoxic functions nk or adcc activities.
Defensins human neutrophil protein hnp 1 2 3 and 4 and serine proteases called serprocidins cathepsin g elastase proteinase 3 and azurocidin cationic antimicrobial protein of 37kda or cap37 as well as two additional antimicrobials with unique primary structureslysozyme and bactericidal. May 21 2017 large granular lymphocyte with azurophilic cytoplasmic granules. These cells normally constitute 15 of circulating leukocytes and are composed of two major subsets. B cell lymphoid neoplasms account for 80 of all lymphoid neoplasms.
May 21 2017 large granular lymphocyte with azurophilic cytoplasmic granules. If you imagine putting a printed page behind the cell the cytoplasm looks as though you could see through it to read the words. Large granular lymphocytes in human peripheral blood. T cell large granular lymphocyte leukemia.